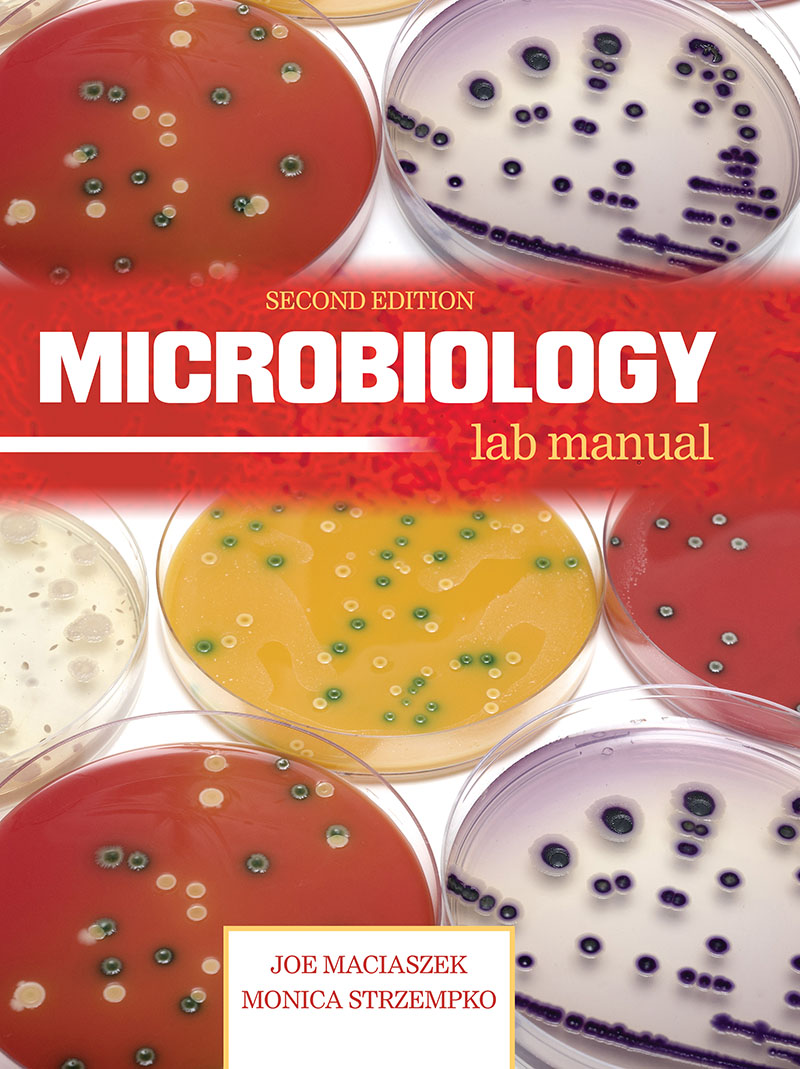
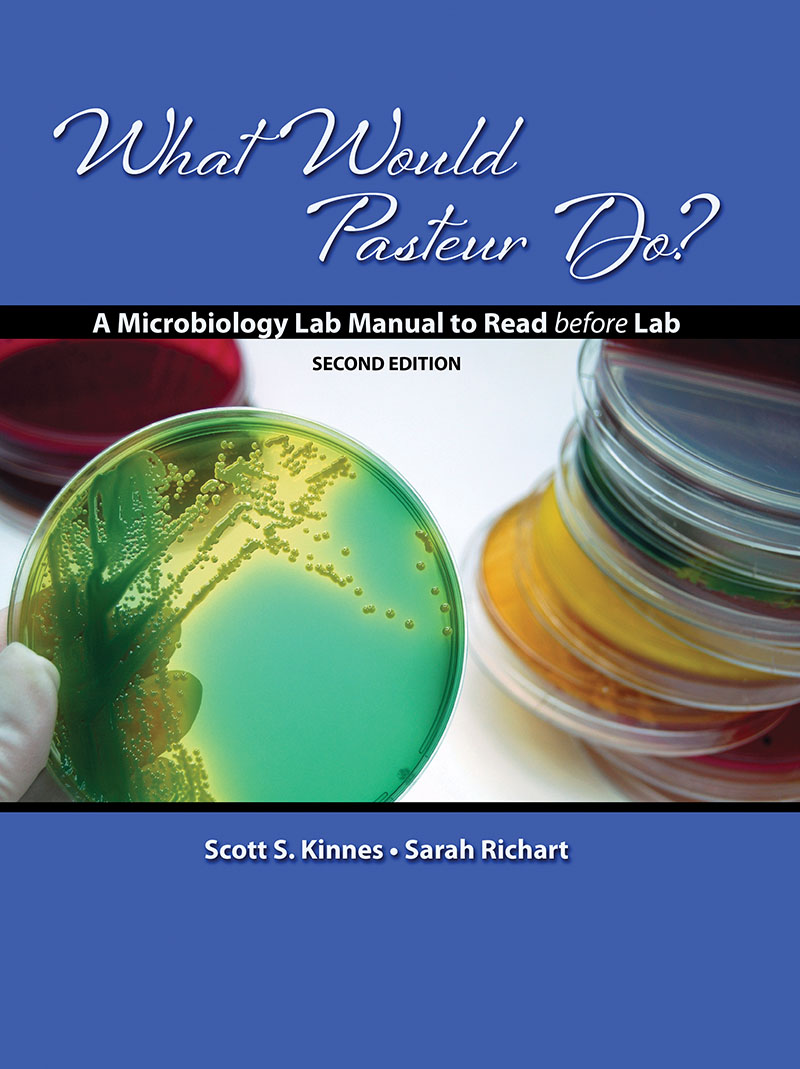

Cellular Biology: Experimental Approaches to Cellular Processes and Molecular Medicine is a turn-key online course package that serves as an introduction and a guide to a student just starting to explore the fascinating world of the cell. It is well suited as a text for a quarter or semester long course taught to upper level biology undergraduates.
Cellular Biology includes coverage of membrane structure and function, protein trafficking between organelles, interactions between the cell and its environment, regulation of the…

The Introductory Biology Lab Manual is for non-science majors. The lab manual has been designed to give students a solid foundation using the scientific method in hands-on labs. The lab exercises are appropriate for 1-2 hour lab sessions or to follow a lecture. The labs are suitable for those students with little hands-on science experiences. The labs have been designed so students have valuable background material prior to beginning the actual labs. The background material can serve as an introduction or pre-lab experience for the…

The eBook version does not include the CD material.

According to the CDC, eight million people die from cancer around the world each year.
In this interactive book, Cancer Biology: An Inquiry-Based Approach examines different characteristics of cancer, and immediately follows up with questions to drive home the material being covered in the chapter.
Cancer Biology: An Inquiry-Based Approach not only covers the types of cancer, but the complexity of treating cancer, how different areas of life can affect cancer, and the history of cancer theories.
Available in print…

Explorative Microbiology is intended to serve as a supplement to the material discussed in Microbiology. It helps students to see the real-world, everyday application of Microbiology.
Explorative Microbiology discusses:
- important molecular biological tools that scientists have harvested from microbes to solve crimes, cure diseases, and do basic research.
- how microorganisms…

Welcome to Disease, Dilemma, and Death: Microbiology Case Adventures. This workbook consists of 18 narrative cases, a case style that emphasizes an engaging, readable story evoking emotion, empathy, and interest—thus serving as an excellent teaching/learning tool. That said, although cases may read as works of fiction, all microbial and clinical data are derived from actual events. These are stories about real people, although a few specifics (names and some locations) have been changed to make them less recognizable. In addition to including disease details, many cases are…
Concepts of Biology…

eBook Version
You will receive access to this electronic text via email after using the shopping cart above to complete your purchase.

eBook Version
You will receive access to this electronic text via email after using the shopping cart above to complete your purchase.
Give your students an inquiry-based approach into laboratory science.
Biology: The Science of Life Laboratory Manual takes a unique approach on the traditional general biology laboratory course. This text provides a more hands-on method with the following course content goals:
- To present, demonstrate, and discuss the…

eBook Version
You will receive access to this electronic text via email after using the shopping cart above to complete your purchase.

eBook Version
You will receive access to this electronic text via email after using the shopping cart above to complete your purchase.

New Revised Printing Now Available!
Now available in a new, revised edition, Human Biology Laboratory Manual explores the basic concepts and principles of the human body and life.
The 19 different exercises progress through the basics of anatomy, reproduction, the complexities of the many systems within our body, and much more. Students will be able to effectively apply concepts, principles, and theories of human biology to make accurate observations and real-time applications.

Cell Biology and Chemistry for Allied Health Science, Sixth Edition, by Frederick C. Ross, is designed to provide the science background in chemical and biological principles that is a prerequisite to anatomy and physiology courses. Your students will find that Cell Biology and Chemistry for Allied Health Science is written in a manner that is helpful and interesting. Each chapter is subdivided into topics and headings. These subdivisions are intended to be logical segments chosen to make learning more manageable.
This new edition contains:
- …


Written ideally for a semester long, general education course in introductory college biology, Biology: Principles and Perspectives, Fourth Edition, by John E. Silvius, offers a biblical, theistic, worldview approach to the study of life science. Biology: Principles and Perspectives provides information to students that allows them to reason analytically and to arrive at their own decisions concerning the origin of life, the environmental crisis, medical ethics, and other issues.
New to this edition of Biology: Principles and Perspectives:
- Improved graphic…

New Revised Edition Now Available!
Welcome to the wondrous, yet unseen, World of Microbiology. Biology 221: Student Study Guide and Laboratory Manual helps students to understand the vast field of Microbiology. As Victory Hugo stated, “Where the telescope ends, the microscope begins, which of the two have the grander view?”
The study of Microbiology is a “high content” subject which will require persistent study and effort throughout the semester. This guide is a great aid to mastery of the course materials.